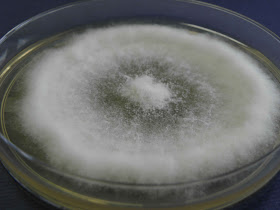

O N. hyalinum é responsável por infecções da planta dos pés, por onicomicoses e infeções sub-cutâneas (neste caso de origem traumática) em regiões de clima tropical.
São fungos responsáveis por dermatomicoses , termo que os separa das dermatofitoses provocadas pelos fungos dermatófitos. Em ambos os casos não há invasão pelo fungo de tecido vivo durante o processo fisiopatológico, muitos dos sinais que evidenciam a patologia são devidos aos produtos metabólicos produzidos.
Este fungo está englobado no grupo dos fungos coelomycetes, é a variadade hialina do Scytalidium dimidiatum. Coelomicetes significa que os conideos são produzidos dentro de um "saco" e não directamente para o exterior do organismos como acontece na grande maioria dos hifomicetes.
Não há muito tempo foi descrito como Hendersonula toruloidea e ainda mais recentemente passou de Scytalidium para Neoscytalidium. Há algumas décadas era também referenciado como a forma telemorfa da Natrassia mangiferae (hoje sabe-se que são espécies distintas). Todos estes nomes ainda são presença frequente na literatura o que pode provocar alguma confusão, as mudanças na taxonomia dos fungos são muito grandes e muito recentes.
A análise macroscópica revela colónias branco-acinzentadas de reverso amarelo-ocre, o crescimento é rápido acabando por preencher a placa de petri, e de textura lanosa.
A análise microscópica do micélio revela a presença de cadeias de artroconideos hialinos e ocasionalmente a presença de picnidia escuras em colónias velhas.
A análise macroscópica revela colónias branco-acinzentadas de reverso amarelo-ocre, o crescimento é rápido acabando por preencher a placa de petri, e de textura lanosa.
A análise microscópica do micélio revela a presença de cadeias de artroconideos hialinos e ocasionalmente a presença de picnidia escuras em colónias velhas.
 |
| Colónia com 48 horas de incubação a 30 graus Celsius. |
 |
| Colónia com 6 dias de incubação. |
 |
| Colónia com 8 dias de incubação. |
 |
| Reverso da colónia. |
|
| Colónia com 20 dias de incubação. |
 |
| Artroconideos. |















Sem comentários:
Enviar um comentário